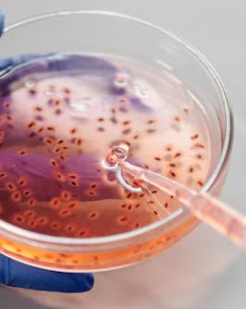

5월 해외여행, 말라리아 조심하세요!
해외여행이 활발해지는 5월, 따뜻한 날씨와 연휴를 활용해 동남아, 아프리카, 남미 등의 열대지역을 방문하는 분들이 많습니다. 하지만 즐거운 여행을 위해 꼭 알아두어야 할 질병 중 하나가 바로 ‘말라리아’입니다. 특히 말라리아는 봄부터 여름까지 유행이 증가하는 경향이 있어, 이 시기 해외여행 계획이 있다면 각별한 주의가 필요합니다.
즐거운 여행이 불안하고 후회되는 여행이 되지 않게 미리 여행을 가기전에 말라리아 예방을 하기 위한 방법을 알아보려면 밑에 사진을 눌러 확인해주세요.

말라리아란 무엇인가요?

말라리아는 플라스모디움이라는 원충에 의해 발생하는 급성 열성 질환입니다. 이 원충은 감염된 *암컷 모기(Anopheles)*에 의해 사람에게 전파됩니다. 모기에 물린 후 혈액을 통해 간으로 침투한 후, 일정 시간이 지나 다시 혈류로 퍼지며 적혈구를 파괴하게 됩니다. 이 과정에서 고열, 오한, 발한 등의 증상이 나타나며, 치료가 늦어질 경우 심각한 합병증이나 사망에 이를 수도 있습니다.
어떤 지역이 위험한가요?



말라리아는 전 세계적으로 연간 수억 명이 감염되며, 주로 열대 및 아열대 기후 지역에서 발생합니다. 특히 동남아시아, 서아프리카, 중남부 아프리카, 남아시아, 남미 일부 지역은 상시 말라리아 위험 지역으로 분류됩니다. 이 중 일부 지역은 말라리아 중증 형태인 Plasmodium falciparum 감염 비율이 높아 더욱 위험합니다.
5월은 특히 동남아 지역의 우기 시작 시기와 맞물려 모기의 번식이 활발해지므로, 이 지역을 여행하는 경우 더욱 주의가 필요합니다.

주요 증상은 어떻게 되나요?



말라리아의 대표 증상은 아래와 같습니다.
- 고열 (39~41도)
- 오한 및 발한
- 두통, 근육통, 피로감
- 구토, 설사
- 빈혈 및 황달 (심할 경우)
감염 초기에는 감기나 독감과 비슷해 방치하기 쉬우나, 말라리아는 증상이 급격히 악화되며 치료 시점을 놓치면 생명을 위협할 수 있으므로 고열이 2~3일 이상 지속된다면 반드시 병원 진료가 필요합니다.
말라리아는 전염성이 있나요?


사람 간 전염은 일반적인 접촉이나 공기를 통해 이뤄지지 않습니다. 반드시 모기를 매개로 하며, 감염된 사람의 피를 흡혈한 모기가 또 다른 사람을 물었을 때 전파됩니다. 하지만 의료시설에서 오염된 주사기나 수혈을 통해서도 간혹 전염될 수 있습니다.
여행 중 어떻게 예방할 수 있나요?


말라리아는 철저한 사전 예방과 여행 중 주의로 충분히 막을 수 있습니다.
- 모기 회피가 최우선
- 해질 무렵부터 새벽까지는 외출 자제
- 긴 소매 옷, 긴 바지 착용
- 모기 기피제(DEET 성분) 사용
- 모기장, 방충망 설치 숙소 선택
- 말라리아 예방약 복용
여행 출발 1~2주 전부터 말라리아 예방약 복용을 시작해야 하며, 여행 중과 귀국 후 일정 기간 복용을 지속해야 효과가 있습니다. 약 종류에 따라 복용 일정이 다르므로 반드시 전문의 상담을 받는 것이 중요합니다. - 귀국 후 증상 지속 시 병원 방문
말라리아는 잠복기가 7일에서 길게는 수주 이상일 수 있으므로, 여행 후 수주 내에 발열 증상이 나타나면 반드시 말라리아 여부를 확인받아야 합니다.
말라리아 예방접종은 없나요?
현재까지 일반적인 말라리아 예방접종은 상용화되지 않았습니다. 일부 백신이 특정 아프리카 지역에서 시범 적용 중이긴 하나, 모든 여행자를 위한 일반 백신은 아닙니다. 따라서 예방약 복용과 모기 회피가 현재로서는 가장 효과적인 예방법입니다. 예방접종 관련 자세한 정보는 별도의 챕터에서 다루겠습니다.
여행은 새로운 문화를 경험하고 힐링할 수 있는 소중한 기회입니다. 하지만 여행 중 건강을 잃는다면 즐거움은 반감될 수밖에 없습니다. 말라리아는 예방이 가능한 질병이며, 사전 정보 습득과 적절한 대비만으로도 충분히 위험을 줄일 수 있습니다. 5월 해외여행을 계획 중이라면 방문 국가의 말라리아 유행 여부를 꼭 확인하고, 사전 준비를 철저히 해 안전하고 건강한 여행을 즐기시길 바랍니다.
'우리몸의 건강와 다양한 정보' 카테고리의 다른 글
| 5월부터 봄에 유행하는 감염병인 홍역과 이하선염, 풍진에 대해 미리 알고 예방합시다. (0) | 2025.04.29 |
|---|---|
| 5월 해외여행 전 말라리아 치료와 예방을 꼭 알아두세요 (0) | 2025.04.29 |
| 5월 해외여행 갔을때 여행자 신분 병원 내원방법과 노로바이러스 대처 방법 (0) | 2025.04.28 |
| 5월 해외여행 계획 중이라면? 해외 병원 내원 방법과 조심해야 할 '노로바이러스'에 쉽고 간편하게 알아봅시다. (0) | 2025.04.28 |
| 5월 해외 여행 뎅기열 예방법과 백신 병원 정보 (0) | 2025.04.28 |